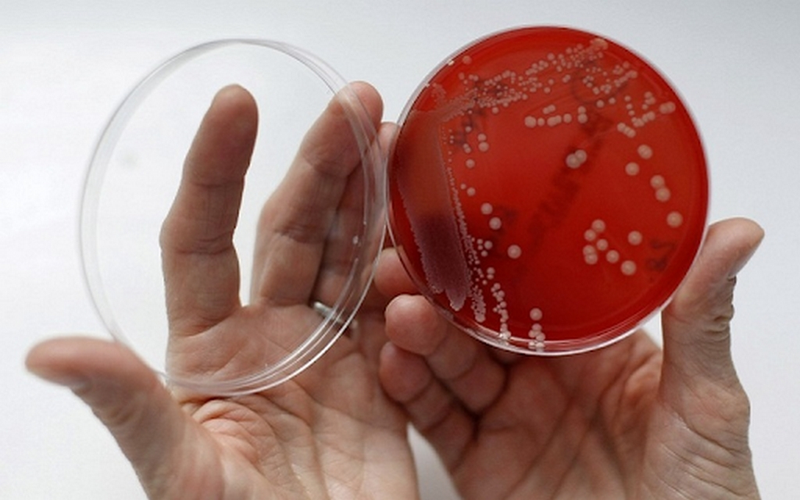
Phac-do-dieu-tri-viem-khop-nhiem-trung 1.png

Tốt nghiệp Khoa Dược trường Đại học Nam Cần Thơ. Có nhiều năm kinh nghiệm công tác trong lĩnh vực Dược phẩm. Hiện đang giảng viên cho Dược sĩ tại Nhà thuốc Long Châu.
Bảo Hân
27/03/2024
Mặc định
Lớn hơn
Viêm khớp nhiễm khuẩn gây tổn thương và hủy hoại khớp, bạn thậm chí có thể phải tiến hành phẫu thuật thay khớp. Để trả lời những vấn đề xoay quanh chủ đề phác đồ điều trị viêm khớp nhiễm trùng mời các bạn cùng đọc thông tin được Nhà thuốc Long Châu chia sẻ dưới đây nhé!
Viêm khớp nhiễm trùng hay viêm khớp nhiễm khuẩn có thể gặp ở bất kỳ đối tượng nào. Bệnh lý này được định nghĩa là viêm nhiễm bên trong khớp do vi khuẩn sinh mủ không đặc hiệu gây nên. Tình trạng nhiễm trùng rất ít khi cùng lúc xuất hiện ở nhiều khớp và thường xuất hiện chủ yếu ở một khớp. Các khớp thường dễ bị vi khuẩn xâm nhập có thể kể đến như khớp hông, khớp gối, khớp vai, khớp khuỷu tay, khớp cổ tay và khớp mắt cá chân.
Màng hoạt dịch khớp có sức đề kháng tương đối yếu nên không thể tránh khỏi nguy cơ bị các vi khuẩn tấn công, dẫn đến tình trạng viêm nhiễm sẽ xảy ra. Có thể phân loại vi khuẩn gây bệnh viêm khớp nhiễm trùng thành hai nhóm chính sau:

Các nguyên nhân thường gặp khác của viêm khớp nhiễm khuẩn là do thay đổi bất thường ở khớp như:
Để chẩn đoán chính xác cũng như xác định nguyên nhân gây bệnh viêm khớp nhiễm trùng cần phối hợp các xét nghiệm gồm:
Xét nghiệm máu: Nhằm kiểm tra các chỉ số viêm trong cơ thể bệnh nhân. Kết quả xét nghiệm thường ghi nhận được tình trạng tăng cao số lượng bạch cầu (đặc biệt là tỷ lệ bạch cầu trung tính), tăng tốc độ máu lắng và CRP. Ngoài ra, khi xuất hiện những nhiễm trùng nặng như nhiễm trùng huyết cũng có thể ghi nhận nồng độ procalcitonin trong máu tăng cao.
Xét nghiệm dịch khớp hay cấy máu: Nhằm xác định vi khuẩn gây bệnh thuộc nhóm nào, từ đó lựa chọn được phác đồ điều trị viêm khớp nhiễm trùng hợp lý.
Chẩn đoán hình ảnh: Tùy từng trường hợp, có thể áp dụng chụp X-quang quy ước, chụp cắt lớp vi tính, siêu âm khớp, chụp cộng hưởng từ hay chụp xạ hình xương. Tuy phương pháp này không giúp chẩn đoán xác định bệnh lý nhưng sẽ góp phần giúp loại trừ một số tổn thương xương kèm theo.
Cơn đau khớp cấp tính khởi phát, có thể có tràn dịch khớp, bệnh nhân đi khập khiễng và các khớp bị ảnh hưởng sẽ gặp khó khăn trong việc cử động. Đi kèm là một số dấu hiệu của tình trạng viêm như tấy đỏ, sưng nóng khớp bị viêm.
Dấu hiệu toàn thân: Bệnh nhân có biểu hiện sốt cao, có thể kèm rét run. Riêng đối tượng trẻ em thường gặp thêm các triệu chứng như chán ăn, bỏ ăn, nhịp tim nhanh, quấy khóc, cảm thấy khó chịu.
Biểu hiện khác: Teo cơ do không vận động, xuất hiện hạch ở các vị trí tương ứng. Tùy vào loại vi khuẩn gây viêm khớp nhiễm trùng mà bệnh nhân có thể xuất hiện một số triệu chứng gồm ban đỏ, viêm bao hoạt dịch gân, mụn mủ trên da hay ban xuất huyết trên da.

Nguyên tắc chung:
Đối với đối tượng chưa có kết quả cấy máu, cấy dịch khớp hay không xác định được vi khuẩn gây bệnh, việc điều trị kháng sinh lần đầu thường theo kinh nghiệm và có thể có sự kết hợp kháng sinh để tăng phổ tác động. Ưu tiên sử dụng các kháng sinh như: Clindamycin, Cephalosporin thế hệ 3, Quinolon, Amoxicillin kết hợp acid clavulanic, Vancomycin (nếu nghi ngờ có tụ cầu kháng methicillin).

Sau khi có kết quả xét nghiệm và xác định được loại vi khuẩn, bác sĩ sẽ đưa ra phác đồ điều trị viêm khớp nhiễm trùng phù hợp với từng bệnh nhân dựa vào kháng sinh đồ, các yếu tố nguy cơ và tình trạng kháng kháng sinh trong cộng đồng, bệnh viện. Để nhanh chóng đạt hiệu quả điều trị, ưu tiên dùng kháng sinh đường tiêm tĩnh mạch trong ít nhất 2 - 3 tuần đầu, sau đó sẽ chuyển sang đường uống nếu có thể.
Lưu ý: Việc dùng thuốc kháng sinh có thể gặp phải một số tác dụng phụ không mong muốn. Vì thế, bệnh nhân không được tự ý sử dụng, tăng liều hay ngưng thuốc đột ngột và nên tham khảo ý kiến của bác sĩ về các tác dụng này trước khi quá trình điều trị bắt đầu.
Chọc hút, dẫn lưu dịch khớp: Phương pháp này có thể được thực hiện mỗi ngày cho đến khi không còn phát hiện vi khuẩn trong dịch khớp.
Nếu chọc hút, dẫn lưu gặp khó khăn hoặc không thành công thì phương pháp được đề nghị tiến hành là nội soi khớp.
Trường hợp diễn biến bệnh kéo dài, bệnh nhân có thể phải phẫu thuật đặt lại khớp.
Mong rằng với những thông tin chia sẻ ở trên sẽ giúp người bệnh có thể biết thêm nhiều thông tin về viêm khớp nhiễm trùng và phác đồ điều trị viêm khớp nhiễm trùng. Do tính nguy hiểm và nghiêm trọng của bệnh nên cần được phát hiện sớm và áp dụng phác đồ điều trị kịp thời để ngăn ngừa những biến chứng nặng nề.
Dược sĩ Đại họcNguyễn Thị Thảo Nguyên
Tốt nghiệp Khoa Dược trường Đại học Nam Cần Thơ. Có nhiều năm kinh nghiệm công tác trong lĩnh vực Dược phẩm. Hiện đang giảng viên cho Dược sĩ tại Nhà thuốc Long Châu.